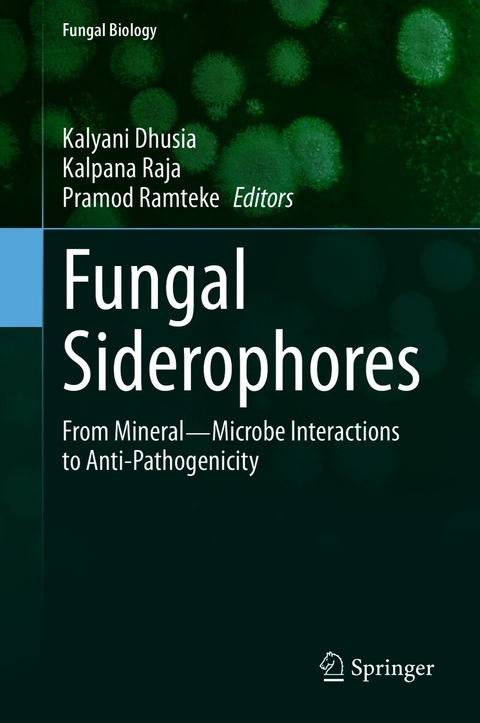
Fungal Siderophores -

Fungal Siderophores (eBook)
X, 216 Seiten
Springer International Publishing (Verlag)
978-3-030-53077-8 (ISBN)
In the past few decades, it has been realized through research that fungal siderophores epitomize the uptake of iron as well as other essential elements like zinc, magnesium, copper, nickel and arsenic. Understanding the chemical structures of different fungal siderophores and the membrane receptors involved in uptake of mineral ions has opened new areas for research. In this edited volume, recent research is presented on fungal siderophores in one comprehensive volume to provide researchers a strong base for future research.
Siderophores are the low molecular weight, high affinity iron-chelating compounds produced by bacteria and fungi. They are responsible for transporting iron across the cell membrane. Fungi produce a range of hydroxamate siderophores involved in the uptake of essential elements in almost all microorganisms and plants. In recent years, siderophores have been used in molecular imaging applications to visualize and understand cellular functions, which thus provide an opportunity to identify new drug targets. Therefore, knowledge of fungal siderophores has become vital in current research.Siderophores have received much attention in recent years because of their potential roles and applications in various research areas. Their significance in these applications is because siderophores have the ability to bind a variety of metals in addition to iron, and they have a wide range of chemical structures and specific properties. For instance, siderophores function as biocontrols, biosensors, and bioremediation and chelation agents, in addition to their important role in weathering soil minerals and enhancing plant growth.
This book focuses on siderophores with the following significant points. It discusses leading, state-of-the-art research in all possible areas on fungal siderophores. The contributors are well-known and recognized authorities in the field of fungal siderophores. It discusses a projection of practical applications of fungal siderophores in various domains. This is the first book exclusively on fungal siderophores. In this comprehensive, edited volume, we show leading research on fungal siderophores and provide the most recent knowledge of researchers' work on siderophores. This book presents in-depth knowledge on siderophores to researchers working in areas of health sciences, microbiology, plant sciences, biotechnology, and bioinformatics.Dr. Kalyani Dhusia is a computational biologist specializing in structural bioinformatics. She earned her PhD in December 2018 focusing on Structural bioinformatics analysis of potential inhibitors against microbial pathogens and joined Michigan State University for her first postdoc in January 2019 where she is focusing her research for development of predictive models of genomic binding by the nuclear receptors, aryl hydrocarbon receptor (AHR) and nuclear factor (erythroid-derived 2)-like 2 (Nrf2) with Bhattacharya's lab.
Her research interest ranges broadly from computational biology, machine learning to artificial intelligence that led to her current position at Albert Einstein College of Medicine that emphasizes on construction of large scale database in with development of machine learning based computational algorithms to study the dynamics of protein protein interaction of membrane receptors in immune systems and their functional role in cell signal transduction.
Her scholarly publications are included in peer-reviewed journals like microbial pathogenesis, infection, genetics and evolution and International journal of biological macromolecules. she is a recipient of national and international awards. She is a dynamic personality and innovator in her field. Her commitment to bring moral courage, ethical conviction and mission statement to the room is spectacular. She keeps looking for innovative and fruitful mergers in interdisciplinary science.
Outside of work she is 6th Kyu Aikidoha with persistently active in traveling, live street music and adventure sports.
Dr. Kalpana Raja has extent knowledge and expertise in pharmacy, software programming, computational biology, bioinformatics and biomedical informatics through education and employment. Basically, she is a pharmacist, awarded with Bachelor of Pharmacy from Tamilnadu Dr M G R Medical University, Chennai, India. Kalpana is a registered pharmacist (life member) with the Indian Pharmacy Council, New Delhi, India. Her interest to develop software tools for healthcare motivated Kalpana to earn Master of Science in Computing: Software Technology from School of Computing, The Robert Gordon University, Aberdeen, Scotland, UK. She completed her second Master of Science degree in Bioinformatics from Bharathiar University, India. Kalpana also completed PhD in Computing: Software Technology - Bioinformatics (inter-disciplinary) from Bharathiar University, India. Recently, Kalpana is honored with Member of Royal Society of Biology (MRSB) from The Royal Society, London, UK. Kalpana gained her post-doctoral training at Department of Preventive Medicine, Feinberg School of Medicine, Northwestern University, Chicago, USA, and Department of Dermatology, University of Michigan Medical School, Ann arbor, USA. Now, she is working as a post-doctoral research associate at Regenerative Biology, The Morgridge Institute for Research, Affiliated with University of Wisconsin-Madison, Madison, USA. Kalpana has published more than 50 research articles in leading journals including Nature Communications, books, and conferences. She has contributed as an editor, associate editor, and reviewer in 10 journals including Briefings in Bioinformatics with impact factor 9.101 and Bioinformatics with impact factor 4.531. In this book, she has applied text mining for microbiology. Though text mining is applied to many biological areas, her attempt to apply it to fungal siderophores is the first application in the field of microbiology.
Prof. Pramod Ramteke has 36 years of research and teaching experience in environmental biotechnology and worked in the area of development of microbe based eco-friendly processes to utilize agricultural wastes for production of biofuels and industrially important enzymes; biodegradation and detoxification of pollutants and sustainable crop production. He worked as Dean of Post Graduateat Sam Higginbottom University of Agriculture, Technology and Sciences (SHUATS) and Scientist at CSIR-Indian Institute of Toxicology Research, Lucknow, India. He obtained three patents, developed 5 databases and deposited 293 gene sequences in NCBI; executed 11 R & D sponsored projects, authored/edited 6 books and published over 250 scientific papers and reviews in national and international peer reviewed journals. He is Fellow of NAAS, NABS, BRSI, AMSc, NESA, UPAAS, MASc, Royal Society of Biology and the Linnean Society of London and has been conferred with Life Time Achievement Award-Dr. B. Vasanthraj David Foundation, Prof. K. V. Shastri Gold Medal, ABAP-Senior Scientist Award, Dr. J. C. Edward Medal, J. C. Bose Gold Medal, SCON Award for Excellence in Science Award, V. S. Chauhan Gold Medal and Prof. K. S. Bilgramy Memorial Award. He was a visiting Scientist at Szeged University, Hungary, Hacettepe University, Turkey, Institute of Food Research, UK, University of Liege, Belgium, Korea Institute of Science and Technology, South Korea and Hydrobiological Institute, Czech Republic.
| Erscheint lt. Verlag | 8.2.2021 |
|---|---|
| Reihe/Serie | Fungal Biology | Fungal Biology |
| Zusatzinfo | X, 216 p. 60 illus., 43 illus. in color. |
| Sprache | englisch |
| Themenwelt | Naturwissenschaften ► Biologie ► Genetik / Molekularbiologie |
| Naturwissenschaften ► Biologie ► Mikrobiologie / Immunologie | |
| Schlagworte | Antipathogenicity • biosynthesis • Fungal siderophore • medical mycology • Metal ion chelation • Soil Remediation • systematic botany |
| ISBN-10 | 3-030-53077-9 / 3030530779 |
| ISBN-13 | 978-3-030-53077-8 / 9783030530778 |
| Informationen gemäß Produktsicherheitsverordnung (GPSR) | |
| Haben Sie eine Frage zum Produkt? |
DRM: Digitales Wasserzeichen
Dieses eBook enthält ein digitales Wasserzeichen und ist damit für Sie personalisiert. Bei einer missbräuchlichen Weitergabe des eBooks an Dritte ist eine Rückverfolgung an die Quelle möglich.
Dateiformat: PDF (Portable Document Format)
Mit einem festen Seitenlayout eignet sich die PDF besonders für Fachbücher mit Spalten, Tabellen und Abbildungen. Eine PDF kann auf fast allen Geräten angezeigt werden, ist aber für kleine Displays (Smartphone, eReader) nur eingeschränkt geeignet.
Systemvoraussetzungen:
PC/Mac: Mit einem PC oder Mac können Sie dieses eBook lesen. Sie benötigen dafür einen PDF-Viewer - z.B. den Adobe Reader oder Adobe Digital Editions.
eReader: Dieses eBook kann mit (fast) allen eBook-Readern gelesen werden. Mit dem amazon-Kindle ist es aber nicht kompatibel.
Smartphone/Tablet: Egal ob Apple oder Android, dieses eBook können Sie lesen. Sie benötigen dafür einen PDF-Viewer - z.B. die kostenlose Adobe Digital Editions-App.
Buying eBooks from abroad
For tax law reasons we can sell eBooks just within Germany and Switzerland. Regrettably we cannot fulfill eBook-orders from other countries.
aus dem Bereich